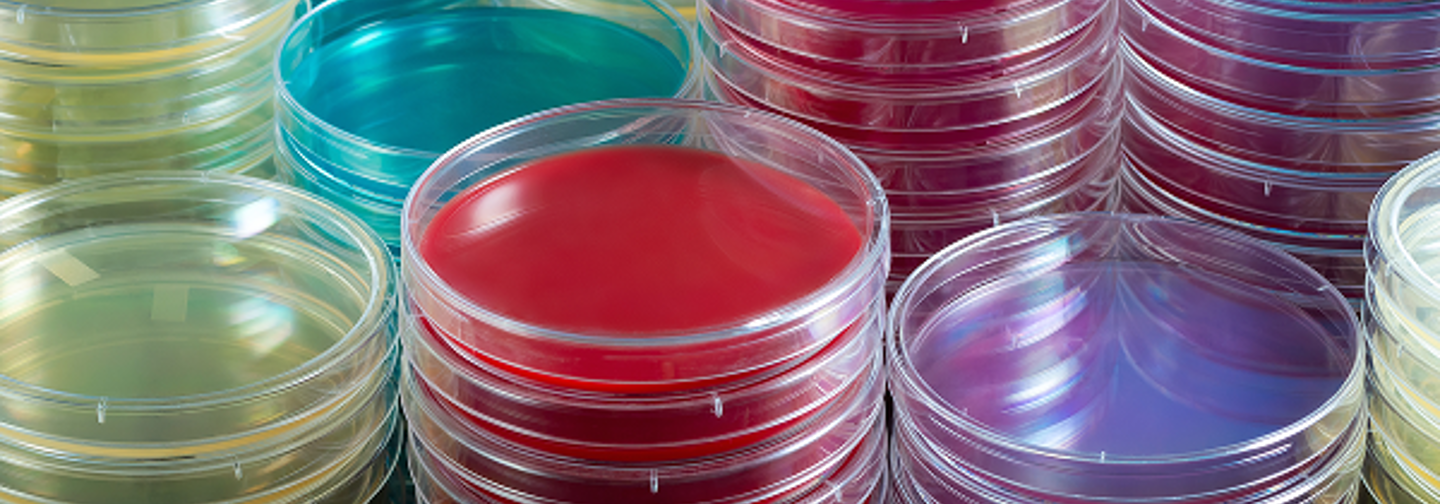
Identification & Detection
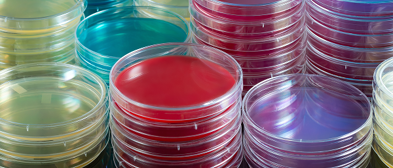
Identification & Detection

Identification & Detection
Accurate identification and detection of micro-organisms are essential in clinical microbiology. Reliable identification methods enable laboratories to differentiate between aerobic and anaerobic bacteria, determine biochemical characteristics, and detect resistance mechanisms with confidence.
Mast Group provides a comprehensive range of identification and detection products designed to support routine and specialist testing in clinical laboratories. These solutions utilise a variety of proven methodologies, including disc testing, biochemical testing, latex agglutination, and agglutinating antisera, ensuring accurate and reproducible results across multiple applications.
With over 65 years of experience, MAST is a trusted partner for clinical and diagnostic laboratories worldwide. This extensive expertise underpins the development of robust, high-quality ID and detection products that deliver confidence in the day-to-day identification and differentiation of micro-organisms.